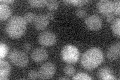
YKL062W
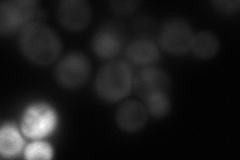
YKL062W
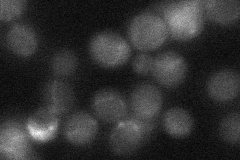
YKL062W
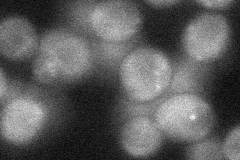
YKL062W

View description
Transcriptional activator related to Msn2p; activated in stress conditions, which results in translocation from the cytoplasm to the nucleus; binds DNA at stress response elements of responsive genes, inducing gene expression
Localization:
Intensity:
Fold change:
Significance:
-
C’ GFP library in SD
below threshold17.84 -
N' NOP1pr-GFP in SD

cytosol63.7964 -
N' TEF2pr-mCherry in SD
cytosolN/A -
N' NATIVEpr-GFP in SD
below threshold21.4193 -
N' TEF2pr-VC and Cyto-VN in SD
cytosol39.0617 -
C’ GFP library in SD+DTT

cytosol19.161.07No -
C’ GFP library in SD+H2O2

nucleus20.141.12No -
C’ GFP library in Starvation Media

cytosol17.720.99No -
C’ GFP library on the background of Pup2-DaMP

below threshold -
C’ GFP library on the background of CCT mutant

below threshold19.50571.09301No
